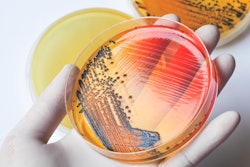

Soybean prices drop, then rise again as market volatility continues to respond to South American forecasts
Soybean and corn prices may have dipped over the weekend, but economists say it’s still too soon to bank on lasting declines amid ongoing market volatility.
Soybean futures fell 60 cents per bushel on Friday alone, according to S&P Global, on news of increased rainfall in Brazil and Argentina, and reports of a new outbreak of African swine fever in China. Prices, however, were quick to rebound, with soybeans running $13.44 per bushel by January 26 after bottoming out at $13.12 on January 22. Corn prices have followed similar trends, dropping to $5.01 per bushel on January 22 but climbing to $5.12 by January 26.
John Baize, a market analyst for the U.S. Soybean Export Council, said the temporary drop in prices was likely the result of a brief sell-off triggered by reports that the upcoming harvest in Brazil and Argentina, which has been delayed due to late planting and poor weather, could exceed expectations.
“The reports say weather in South America is going to be great. As a general rule, the market goes up slower than it goes down, so I think people took their profits on Friday,” Baize said. However, by Monday, the forecast had changed and called for additional inclement weather, reversing the trend.
Although prices for both corn and soybeans are now near historic highs, Baize said producers can expect market volatility to continue until the South American harvest is complete and yields a known quantity. As it stands, Baize said, producers can expect to see rapid turns in the market in response to tight supplies and uncertainty about when U.S. stocks will leave the industry with greater room for error.
“They’re predicting we will pull down stocks to 140 million bushels, which is historically low,” he said, “and the market is saying we need to ration that supply.”
Baize said he expected current market conditions to last at least six weeks, through the end of harvesting in Brazil and Argentina. Initially delayed by dry weather, Baize said farmers in those countries are now experiencing a delayed harvest due to untimely rains. After that, he said, attention will turn to crop projections in the U.S., where competitive prices for corn could sway farmers away from planting soybeans, further tightening supplies if the South American harvest doesn’t come through in full.
The situation, Baize said, highlights a need for feed and grain producers to adopt “sophisticated hedging techniques to cover cost for inputs.”
“There’s not much you can really do if you’re not covered,” he said. If “you’re buying feed ingredients right now, you’ve got a problem.”